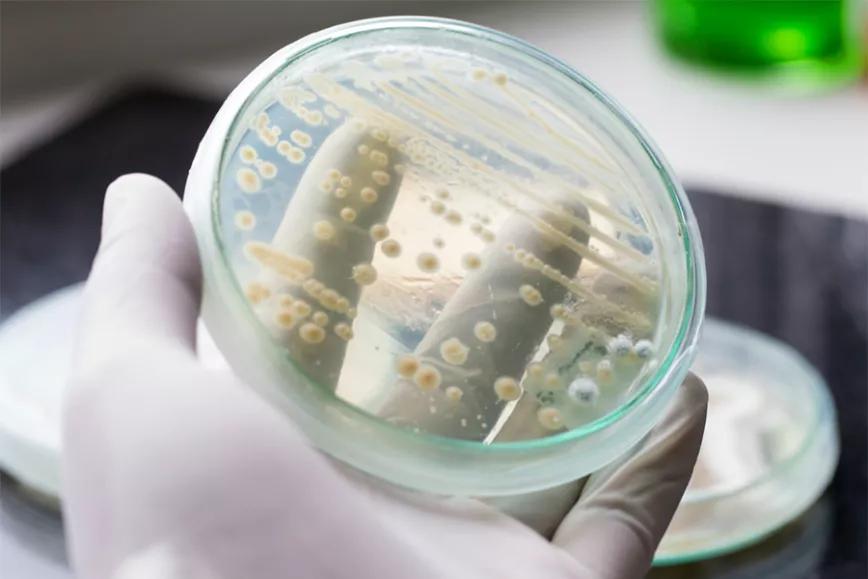

La química es maravillosa. Dos moléculas de un componente son siempre iguales. Por tanto, da igual que la molécula de THC la haya producido un cogollo u otra cosa. Esto implica, como ya sucede, que se puedan crear diferentes cannabinoides en “laboratorio”. Utilizar otros productos para generar de forma más rápida, eficiente y masiva un cannabinoide específico.
Algunas compañías buscan saltarse la ley de los EE.UU que prohíbe o bien el THC o el CBD (según el estado, según la legislación, etc). Su estrategia consiste en buscar otros cannabinoides más raros, que no estén legislados, y que puedan producirse en masa mediante un proceso químico en lugar de mediante el cultivo de cannabis. Los hongos de las levaduras son un prometedor candidato par producir en masa estos cannabioides y no ser perseguidos por la ley.
Los hongos de la levadura se producen mediante bacterias muy específicas. Estas levaduras son las más utilizadas en la biofarmacología junto con la bacteria E.Coli. Esta última, irónicamente, es una de las bacterias más peligrosas en entornos donde no existe un sistema de sanidad sólido. Por otra parte La E.Coli vive con nosotros desde hace muchos años ya ayudándonos en otras tantas cosas.
La carrera científica se sitúan en el espacio de encontrar o bien nuevos canabinoides o bien viejos conocidos que sean diferentes al CBD o al THC pero tengan propiedades similares. Par aun científico que trate de buscar estos productos no importa cómo se produzcan, lo importante es la consistencia y confiabilidad del suministro, no si este se ha producido con la luz solar y en el suelo de cultivo.
Dementrix es una empresa que se dedica a esto: buscar la producción masiva de estos cannabinoides usando en el proceso a hongos de la levaduras. Demetrix ha identificado el primer cannabinoide llamado “raro” que quieren llevar al mercado. Bryant no mencionó el cannabinoide específico que la compañía planea lanzar al mercado el próximo año, citando secretos comerciales, y solo dijo que "descubrieron algunos efectos útiles".
¿Serán los cannabinoides de “laboratorio” el futuro de todo esto?